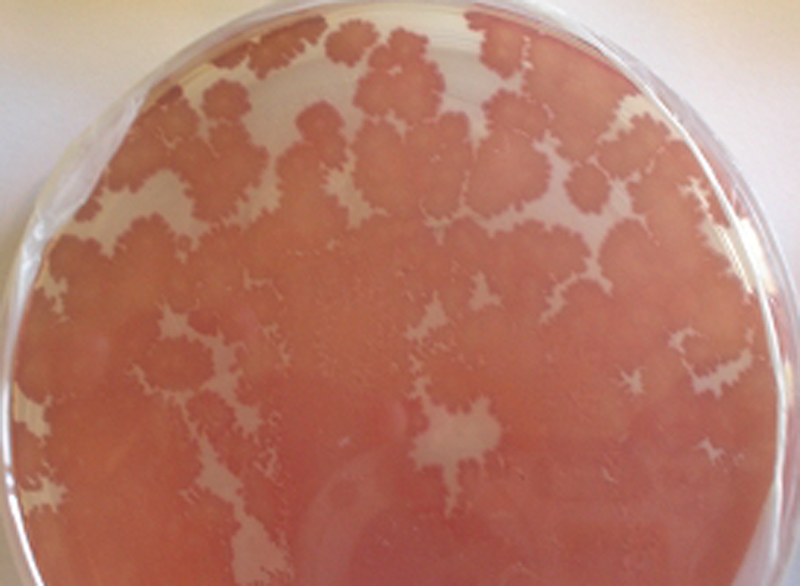

Vibrio vulnificus: Métodos para detectarlos con mayor fiabilidad
Vibrio vulnificus: Detección e identificación más certeras mediante mejores medios de enriquecimiento, aislamiento e identificación
INTRODUCCIÓN (para poner los pelos de punta)
Vibrio vulnificus es un grave patógeno propio del mar y de las aguas hipersalinas que se acumulan tras las playas.
Infecta por ingestión de productos del mar contaminados por él. Nada menos que el 50% de estas infecciones, en el caso de la mala costumbre de ingerir bivalvos crudos recolectados en la playa (aunque les echemos limón), acaban en la muerte del afectado.
Y también es un grave patógeno por infección de heridas al bañarse en agua hipersalinas estancadas.
Se encuentra en playas, rocas y maderas en contacto con agua salina semi estancada, y resulta patógeno al introducirse en una herida.
Muchos de estos casos terminan con septicemias y muertes; basta una apertura en la piel para que causen cuadros de gravedad en uno de cada cuatro infectados.
Nada menos que 1 de cada 5 personas que sufren estas infecciones a través de heridas acaban muriendo por ello.
Detección tras enriquecimiento
Como buen Vibrio, es Oxidasa + y Lactosa +. Pero además, esta especie es halófila (crece hasta con 60 g/l de ClNa o aún mejor: sales marinas DMT149, y no crece sin al menos 20-37 g/L).
Por ello los medios de enriquecimiento más efectivos (a menudo el paso previo necesario para detectarlo cuando está a bajas concentraciones), son hipersalinos:
El clásico:
https://www.microkit.es/fichas/ALKALINE-SALINE-VIBRIO-ENRICHMENT-BROTH.pdf
No confundir con este otro, más indicado para V.cholerae:
https://www.microkit.es/fichas/ALKALINE-VIBRIO-ENRICHMENT-BROTH.pdf
La aportación de MICROKIT que mejora al Alkaline-Saline:
https://www.microkit.es/fichas/VIBRIO-HIPERSALINE-MICROKIT-BROTH.pdf
Un truco importante en Vibrio es preenriquecer-revitalizar en TSB para eliminar el stress.
Este preenriquecimiento-revitalización de unos minutos en TSB permite la detección un 50% más veces que si no se hace.
https://www.microkit.es/fichas/TSB-TRYPTIC-SOY-BROTH-polvo.pdf
Tras enriquecer, hay que aislar estriando en placa
También los medios clásicos de aislamiento mejoran su selectividad para este vibrio añadiéndoles 20-50 g/L de ClNa…
…o mejor aun, de sales marinas (agua de mar desecada) DMT149, ya que aumentan no sólo la presión osmótica necesaria como hace el ClNa, sino que además aportan todos los oligoelementos necesarios:
https://www.microkit.es/fichas/AGUA-DE-MAR.pdf
En el clásico TCBS V.vulnificus se distingue porque no fermenta la sacarosa, por lo que crece con colonias verde-azuladas, no amarillas:
https://www.microkit.es/fichas/TCBS-VIBRIO-AGAR.pdf
Otro medio de aislamiento en placa, muy recomendable para distinguirlo de V.parahaemolyticus y de V.alginolyticus es el TSAT, basado en TTC:
https://www.microkit.es/fichas/VIBRIO-TSAT-SALINE-AGAR.pdf
ya que en el mismo, V.vulnificus crece con colonias crema o incoloras, mientras V.parahaemolyticus y Vibrio alginolyticus crecen con colonias rojas o blancas.
.
Otro medio que aporta MICROKIT es la versión agarizada del caldo antes indicado para halófilos:
https://www.microkit.es/fichas/VIBRIO-HIPERSALINE-MICROKIT-AGAR.pdf
Y el medio cromogénico (al que puede ser conveniente añadir 25 g/L de ClNa o de sales marinas (agua de mar desecada) DMT149:
https://www.microkit.es/fichas/CROMOKIT-VIBRIO-AGAR.pdf
Confirmación de colonias sospechosas
Como siempre, los medios de aislamiento nos acercan pero no son 100% específicos, de modo que hay que confirmar las colonias sospechosas.
https://www.microkit.es/fichas/CITOCROMO-OXIDASA-M-IDENT-ISO-16266–ISO-16649.pdf
o bien:
https://www.microkit.es/fichas/Citocromo-oxidasa–reactivo-en-goteros-para-banar-placas.pdf
También ofrecemos las galerías de identificación enzimática a nivel de especie en sólo 4 horas Rapid NF:
https://www.microkit.es/fichas/Galerias-RAPID.pdf
.
También tenemos una completa gama de medios y kits de confirmación para V.cholerae, V.parahaemolyticus, V.alginolyticus…
Solicite los precios actualizados en microkit@microkit.es
Si tiene dudas técnicas contacte con consultastecnicas@microkit.es
Haga sus pedidos en pedidos@microkit.es